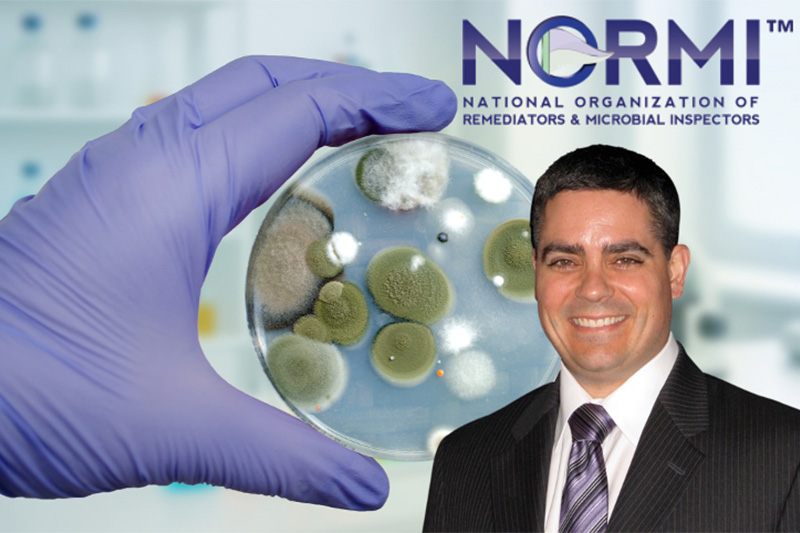
Dr. Andrew Heyman

Closing the Gap Between Remediation Best Practices and Clinical Reality
For years, mold remediation and medical treatment have operated in parallel lanes. Cleaning and restoration professionals addressed the built environment, while physicians treated patients, often without fully accounting for patients’ home environments. That separation is no longer sustainable, claims Dr. Andrew Heyman, MD, chair of the National Organization of Remediators and Microbial Inspectors’ (NORMITM) Medical Advisory Board.
“Mold exposure is still not well recognized within conventional medicine,” Heyman said. “The way mold exposure is seen within the medical system is still largely based on the 2004 recommendations that it is either an allergic response or, at worst, a pulmonary issue. The world has moved on.”
An evolving understanding of mold-related illness
Heyman explained that research over the past two decades has expanded the understanding of mold-related illness well beyond allergies. Clinical evidence now shows that microbial exposure can trigger complex inflammatory responses with wide-ranging effects on multiple body systems. In some individuals, those responses are severe.
“When you realize the degree to which people can be affected by these exposures, and how lives can be truly harmed as a result, you have to look at the environments in which people live,” Heyman explained. “You cannot understand these patients outside of that context.”
That realization reshaped his view of remediation professionals. Rather than seeing remediators as ancillary service providers, Heyman described them as part of the patient’s front line of care. “I now think the remediator is part of the primary care team for that patient,” Heyman acknowledged. “They are not just an ancillary professional. They are going to see things other people do not, and they will often interact with that client far more than I ever would.”
Integrating clinical insight into remediation practices
This perspective directly influenced the development of NORMI’s LEVEL 4 Protocol for Assessment and Remediation. Heyman said the protocol was designed for cases involving medically sensitive individuals who do not respond to conventional remediation approaches.
“There are people who are genetically predisposed to become very sick from these exposures,” Heyman noted. “For those individuals, the techniques applied to the home need to be elevated and more aggressive. The role of the remediator becomes central, and it is a role that needs to be taken seriously because it is about a person’s health in deep and meaningful ways.”
The LEVEL 4 protocol integrates remediation practices with clinical insight, acknowledging that environmental intervention and medical treatment must work together. Heyman expressed that this collaboration emerged from years of observing better patient outcomes when investigators, remediators, and clinicians communicated effectively. “My best clinical outcomes were always when I worked closely with investigators and remediators,” Heyman added. “I had to learn to speak their language, and they have to learn to speak mine.”
That need for shared understanding was a key reason NORMI established its Medical Advisory Board. Heyman said the timing reflected advances on both sides of the equation. “We are now much better able to measure the impact of the home on its inhabitants clinically,” Heyman said. “We are also better at treating them. But no amount of treatment will work if the home is not dealt with properly.”
The board’s role is to ensure that medical science aligns with remediation standards, training, and competencies. Heyman emphasized that standardization is critical. “It is no good if you have 20 remediators doing 20 different things,” he said. “If outcomes are going to be reliable and understandable, professionals need to be moving in the same direction.”
Closing the gap between medical recognition and environmental reality
From Heyman’s perspective, one of the most significant gaps in the industry is not remediation itself but medicine’s failure to fully recognize and validate mold-related illnesses.
“We have not taken the health impact of a contaminated home seriously,” Heyman stated. “Where medicine has fallen short is believing patients and having reliable measurement tools to demonstrate that they are objectively sick and that the home is the cause.”
He noted that new biomarkers and diagnostic tools are beginning to close that gap. These advances challenge traditional toxicology models that assume higher exposure equals greater harm.
“The immunologic model shows that even minute amounts of exposure can lead to enormous inflammatory responses,” Heyman reported. “You can have someone with relatively low measured mold levels who is profoundly ill. That does not fit the old model, but it fits the new science.”
This shift has significant implications for high-risk environments, including schools, healthcare facilities, military housing, and athletic facilities. Heyman cited repeated clinical patterns where environmental exposure contributes to neurological inflammation, cognitive impairment, and behavioral changes.
“I see children labeled with learning disabilities when it is actually the environment affecting them,” he said. “These are critical populations that deserve a level of attention and care they are not currently getting.”
Looking ahead, Heyman expects rapid acceleration in the field, driven by advances in molecular biology, genomics, and immunology. He believes these tools will reshape how practitioners understand individual susceptibility and response to environmental exposure.
Ultimately, he commented, success will be measured by outcomes, not theory. “We will be able to answer two questions: What did we do for the home, and what did we do for the people living in the home,” Heyman said. “That will elevate the role of the remediator, elevate the role of the practitioner, and finally put the patient at the center.”
For Heyman, the stakes extend beyond industry improvement. “There are millions of people affected by their homes,” he reported. “If we get this right, it may be one of the most important advances in modern medicine.”
To learn more about NORMI’s efforts to bridge the built environment to the healthcare industry with NORMI’s Level 4, medically directed protocol, visit NORMIPro.com. For any who feel they may have health issues with mold or other indoor air quality concerns, follow the prompts on that page.












